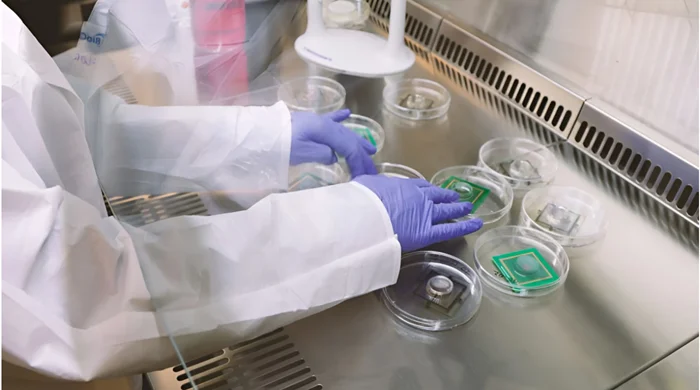

Биоинженерия будущего: создание живых биокомпьютеров из клеток мозга
Что общего у искусственного интеллекта и пробирки с питательным раствором? На первый взгляд, ничего. Но только представьте: ИИ черпает свою мощь не из холодного кремния, а из живых клеток человеческого мозга. Звучит как завязка фантастического фильма. Однако реальность, как и часто бывает, куда интереснее любого вымысла.

Швейцарский стартап FinalSpark для выполнения сложных вычислений уже предлагает всем желающим арендовать... настоящие мозги. Ну, или почти.
Компания создаёт так называемые биокомпьютеры, в основе которых органоиды мозга — скопления живых нейронов, выращенных из стволовых клеток. И да, эти мини-мозги уже учатся, решают задачи и, возможно, даже «видят» сны.
Живой мозг vs. Компьютер
Чтобы понять, почему FinalSpark выбрали столь необычный «процессор» для своих биокомпьютеров, давайте вспомним, как работает наш собственный мозг.
В отличие от привычных компьютеров, которые обрабатывают информацию линейно, шаг за шагом, наш мозг многозадачен. Миллиарды нейронов, соединённых синапсами, постоянно обмениваются электрическими импульсами, образуя сложнейшую сеть. Такая нейронная сеть позволяет нам учиться, мечтать и писать статьи для блога (ну, по крайней мере, мне) :)
Современные компьютерные нейросети, в какой-то мере имитируют работу живого мозга. Однако при этом поглощают электричество в огромных количествах. Обучение одной модели может стоить миллионы и миллиарды долларов, а количество выделяемого при этом тепла способно обогреть небольшой город.

Органоид мозга под микроскопом
Если для выполнения какой-то задачи компьютерной нейросети потребуются — мегаватты электроэнергии, то живому мозгу несколько десятков ватт. Так и с органоидами: они, хоть и в тысячи раз меньше человеческого мозга, показывают феноменальную энергоэффективность, оставляя кремниевых конкурентов далеко позади.
Мозги на кремниевом чипе
FinalSpark предлагает следующую технологию изготовления процессоров нового типа: крошечные органоиды мозга, выращенные из стволовых клеток, помещаются в питательный раствор и подключаются к кремниевому чипу с помощью электродов. Получается эдакий мозг-киборг, способный как принимать информацию извне, так и отправлять сигналы обратно. Но как же научить его решать поставленные задачи?

Четыре органоида человеческого мозга (в каждом около 10 000 живых клеток) подключены к биокомпьютерному массиву
Всё гениальное просто: нейроны по своей природе стремятся к порядку и предсказуемости. Создавая для органоидов виртуальную среду с помощью электрических импульсов, учёные FinalSpark могут «награждать» их за правильные решения и «наказывать» за ошибки.
Кстати, о наградах. FinalSpark добавили в свою технологию интересный нюанс - «дофаминовую мотивацию». Помните чувство удовлетворения от решения какой-то сложной задачи? Так вот, органоиды испытывают нечто подобное, когда получают порцию дофамина — гормона удовольствия. Хитро придумано, правда?
Интересно, что FinalSpark - не единственные, кто решил использовать мозговые клетки. Австралийская компания Cortical Labs пошла ещё дальше, создав устройство DishBrain, где 800 000 нейронов, выращенных на чипе, умудряются играть в Pong. Ту самую пиксельную классику 70-х. Причём учатся они этому всего за 5 минут, что не может не впечатлять.
Возможности и риски
Вообще, биокомпьютеры открывают огромные перспективы. Например, создание сверхэффективных систем машинного обучения, способных решать сложнейшие задачи за доли секунды, не потребляя при этом энергию целой электростанции. Или новые методы тестирования лекарств, позволяющие прогнозировать их эффективность и побочные эффекты с невиданной ранее точностью.
Органоиды, подключенные к кремниевым чипам должны находиться в питательной среде и стерильных условиях с поддержанием необходимой температуры
Однако не стоит забывать и об этической стороне медали. Подобные технологии неизбежно вызывают целый шквал вопросов, главный из которых — насколько этично использовать живые ткани для обучения искусственного интеллекта? Имеем ли мы право манипулировать живыми клетками, пусть и не обладающими сознанием в полном смысле этого слова?
Вопрос, конечно, сложный. С одной стороны, человечество давно использует живые организмы в своих целях. Благодаря дрожжам у нас есть хлеб и пиво, ну а лошади веками трудятся бок о бок с человеком. Так чем же органоиды хуже?
С другой стороны, манипулирование мозговой тканью — это уже совсем другой уровень ответственности. И хотя учёные уверяют, что органоиды не испытывают страданий и не обладают сознанием в привычном нам понимании, кто может гарантировать, что это так на самом деле?
Будущее биокомпьютеров
Как бы то ни было, развитие биокомпьютеров — это уже реальность. FinalSpark собирается предлагать доступ к своей технологии через облачный сервис, что сделает её доступной для широкого круга клиентов. Поэтому, возможно, уже совсем скоро мы будем жить в мире, где самые мощные компьютеры работают на... мозгах, выращенных в лаборатории.
Конечно, говорить, что GPT-5 будет обучаться на клетках человеческого мозга, пока ещё рано. Однако в свете всего сказанного, такая возможность уже не кажется чистой фантастикой.
Более того, биокомпьютеры могут стать настоящим спасением для нашей планеты. Проблема энергопотребления дата-центров становится всё более острой, и именно биокомпьютеры, с их феноменальной эффективностью, могут стать ключом к её решению.